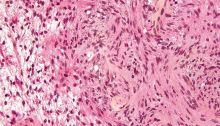

NTP, Ramazzini, plus qu’une coïncidence
Source : More Than a Coincidence – Microwavenews.com – 20/02/2018 New Large Animal Study, Like NTP’s, Links RF to Schwannoma of the Heart C’est arrivé encore une fois Une seconde étude scientifique de grande envergure a trouvé des tumeurs au niveau des cellules de shwann (schannome) situées au niveau du cœur de rats mâles exposés…